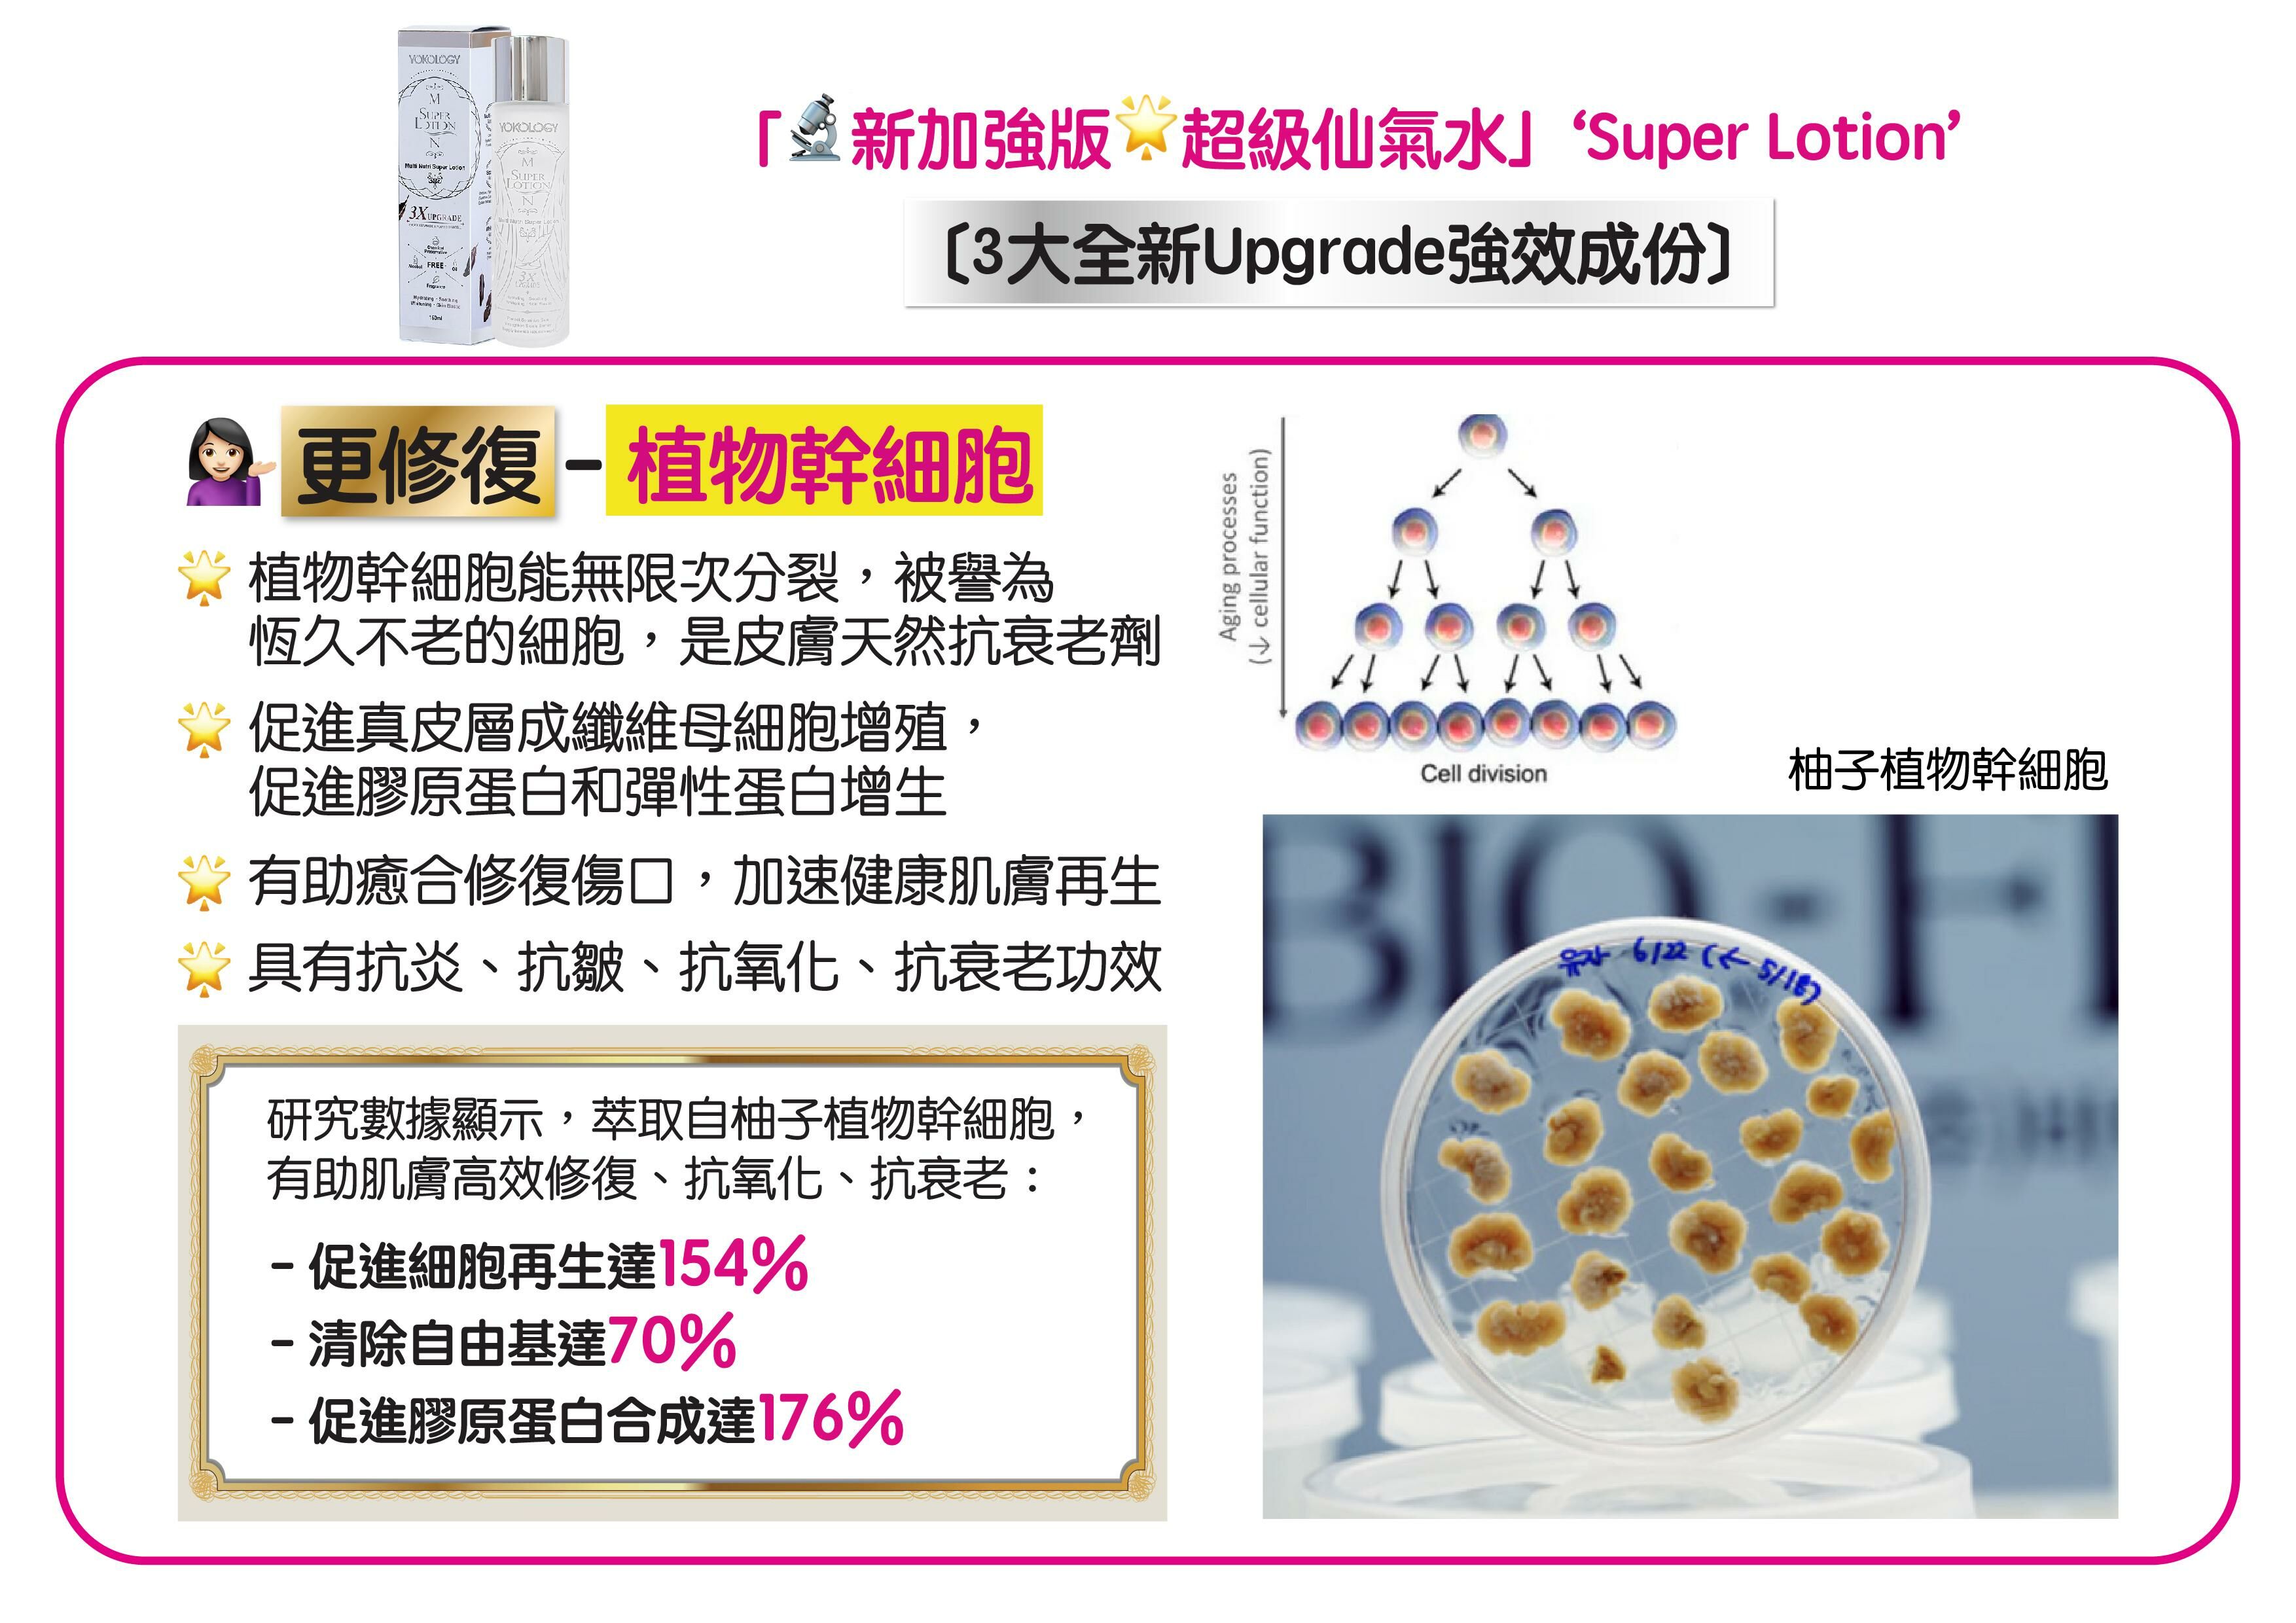

新增3X Upgrade超級成份
更紓敏!更保濕!更亮白!更修復!
簡介:
大受好評「仙氣水」,新升級至「超級仙氣水」!
3大全新Upgrade強勁成份 = 超級紓敏「積雪草」x 超強保濕「神經醯胺」x 超高效修復「植物幹細胞」,配合原有王牌韓國大廠專利甲殼素、KFDA認證美白成份、水解膠原蛋白肽及多種亮點修護元素,完美調配黃金比例,加上韓國嶄新注滲技術,成就全新3X Upgrade版「超級仙氣水」登場。
「超級仙氣水」一抹瞬間吸收,極速滲入肌底,是你潔面後護膚極重要第一步。萬能功效,有效紓敏褪紅、保濕防乾、美白亮澤、增加皮膚彈性,天然抗炎防治暗粒。專為脆弱受損肌膚提供高效呵護,亦為後續保養程序打好根基,養成海綿膚質,皮膚自然飽滿富光澤又健康!
「超級仙氣水」不含任何化學防腐劑、香料、色素、酒精、油份,通過微生物安全檢測,溫和高效;濕敏肌膚、醫學美容後、懷孕期和小朋友都適用。
超級卓越 八大療效
.保濕防乾.紓敏褪紅.美白亮澤.天然抗炎
.防治暗粒.增加彈性.柔軟肌膚.維繫健康
「超級仙氣水」由韓國專門生產及製造甲殼素成份的廠商研發,亦為韓國最大甲殼素原材料供應商之一,擁有3項甲殼素專利生產技術,並獲ISO9001/ISO14001/HACCP三項高標準的化妝護膚品生產認證。
=======================================
〔使用方法〕
.早晚日常護理
潔面爽膚後,將「超級仙氣水」倒於掌心,塗抹面、眼、頸,再進行後續護膚步驟
.加強保濕鎖水法
塗精華素後,將4滴「超級仙氣水」+ 4滴護膚油,於掌心混合,塗抹上面(之後可再配合面霜)
*頸部塗抹方法相同
.配合面霜獨特法
將數滴「超級仙氣水」混合面霜,可稀䆁濃杰乳霜,更易吸收,及有助預防暗粒,建立舒敏屏障
.速效敷面法
將「超級仙氣水」滲透化妝棉,敷在皮膚特別需要注養位置1分鐘 - 如眼底、額頭、極乾燥面頰、敏感泛紅脫皮位置,無需清洗,之後如常護膚步驟,肌膚問題迅速驟減。
敷上乳霜狀或片裝面膜前,先抹上「超級仙氣水」,令滲透力加強,營養雙得益彰。
.加強療效法
將「超級仙氣水」注入噴霧式小瓶 或 美肌噴霧儀,隨時隨地噴灑於眼面頸加強保濕,亦非常適合用於補妝前
- 塗粉底液前噴於肌膚,有效補水減少油脂過盛,令妝效更持久
- 撲碎粉後,噴於肌膚,立即趕走乾燥乾紋,提升水潤感也更貼服
=======================================
〔天然抗炎抗敏成份〕
韓國專利甲殼素(Chitosan)
.採用頂級專利萃取技術,煶煉出超級純正的甲殼素成份,來自韓國紅雪蟹
.超卓天然抗炎抗敏絳紅紓緩功效,有助修復皮膚細胞,築起健康皮脂膜
.保濕鎖水功效同樣超卓,能避免肌膚流失水份,保持肌膚柔軟潤滑
*專利註冊編號:0491683
※對海鮮敏感人士亦可安心使用,因海鮮敏感源於食用海鮮中蛋白質所致;而用於護膚產品的純正甲殼素,經提煉後不含蛋白質。
〔KFDA認證美白成份〕
韓國KFDA認證熊果素(Arbutin)
.韓國KFDA認證美白成效(濃度達特定標準)
.可阻止令黑色素生成的酪胺酸脢(Tyrosinase)活化,並阻斷其酵素活性,抑制皮膚黑色素生成,阻擋紫外線的傷害,達致美白、淡斑、袪印,改善暗啞等效果,塑造亮白剔透水光肌
.淡斑效果更被視為眾多美白成份中最顯著
.「超級仙氣水」選用的α熊果素,以酵素分解而成,成份天然,成本亦較高昂,其美白及亮澤肌膚效果比β熊果素優勝十倍以上,致敏度亦相對β熊果素(化學合成)為低,敏感肌和醫學美容後可安心使用
韓國KFDA認證維他命B3(Niacinamide)
.高美白成效經韓國KFDA認證
.可阻截黑色素傳遞,並減少肌膚於照射紫外線後製造黑色素,令肌膚透白亮澤
.可維持肌膚含水量,有效改善細紋及維繫健康
.研究顯示,有助抗炎及減少油脂分泌,從而阻止發炎性青春痘
.高效抗炎,增加皮膚屏障能力,對敏感肌膚、脂漏性皮膚炎患者都是很好的保養成份
〔高效亮點成份〕
透明質酸
.最強保濕成份之一,快速滲透肌膚
.能提高皮膚水份及彈性,消除細紋、乾紋,達致抗皺、防衰老
8種天然植物萃取成份
.供給肌膚多種天然修護養份
-------------------------------------------------------------